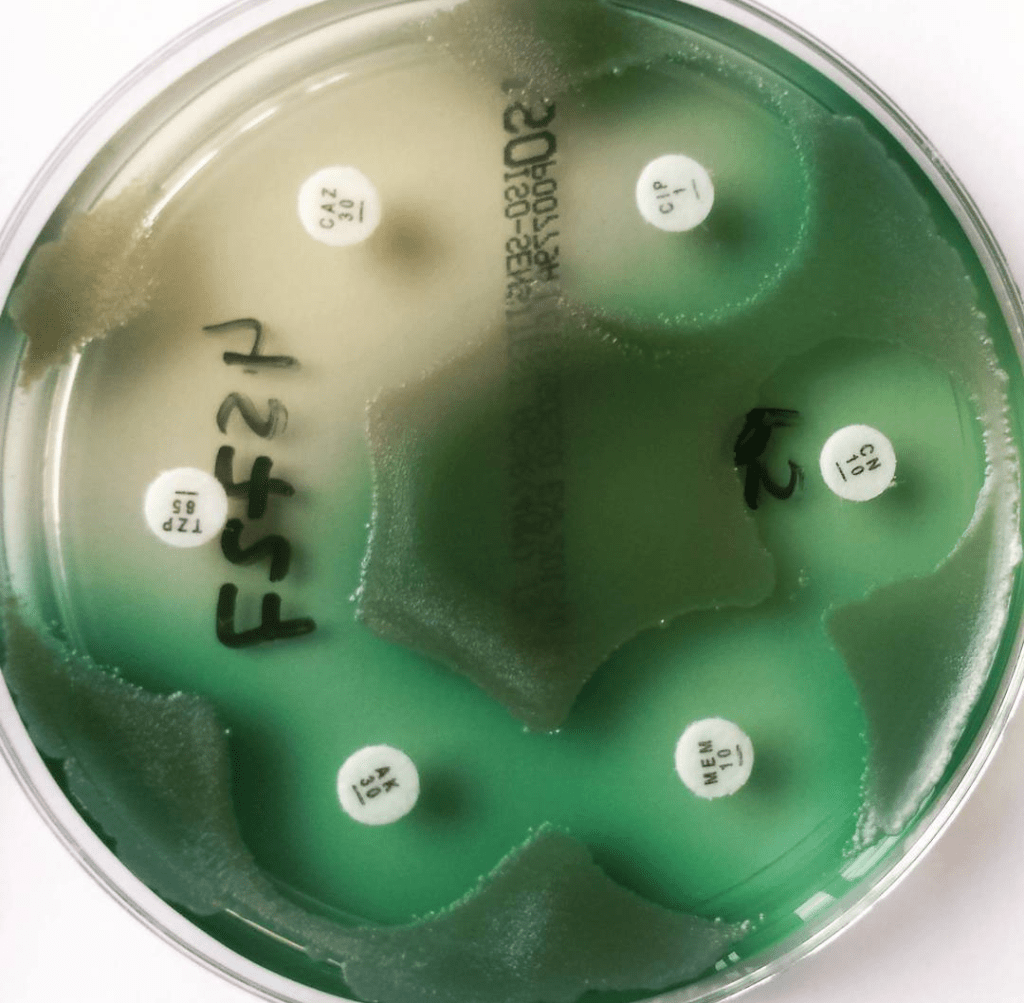

The 2021 meeting is themed around ‘Designing and building for infection prevention’
With ventilation and building design firmly in the national and international spot light linked to SARS CoV2, how can we design our healthcare facilities better to reduce transmission risk. What skills and knowledge do we need to understand what it is that we don’t know and ask the questions that need to be asked?
The structure of the day and the remit of the network was developed based on the results of a survey that was distributed through a variety of professional bodies and networks.
Meetings are structured with a number of lecture based sessions in the morning slot and case studies in the afternoon (see the case studies page for the case studies from all meetings).
The set up of the day focusses on shared learning and network development, so we can help support each other across the challenges that the environment can present.

Presentations from the day
Infection Prevention and the built environment: the good, the bad and the time consuming
Dr John Hartley
Building a new hospital: Complications and lessons learnt
Dr Christine Peters and Dr Teresa Inkster
What to do with your environment when re-design is not an option?
Martin Kiernan
Staphylococcus capitis, the new kid on the environmental block?
Dr Derren Ready
How do risk assessment and governance support new build safety?
Elise Maynard
What role does education play in supporting infection prevention and control teams in managing the built environment?
Dr Lena Ciric